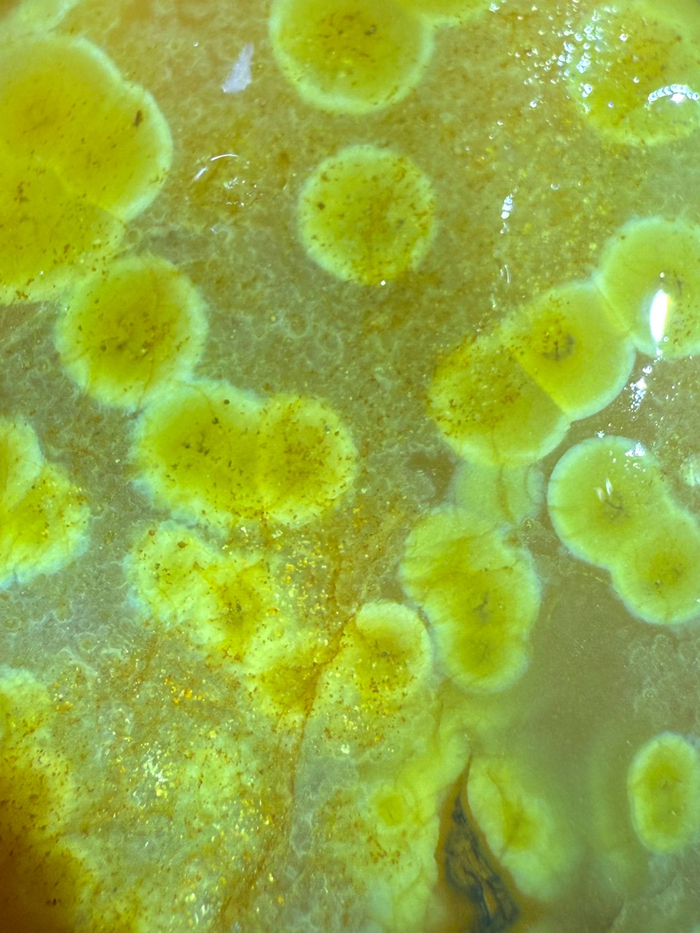
Агат с халцедоновыми шариками.

Самая большая оса России. Насколько она опасна?
Думаю, что мало кто из людей любит ос. Особенно, когда они роятся возле тебя. Но ещё меньше энтузиазма (если вы, конечно, не энтомолог) вызовет у вас оса в несколько раз превышающая в размерах обыкновенную.
Многие люди ошибочно принимают её за шершня, что только добавляет подозрительности к этой представительнице мира насекомых. Так кто же эта прекрасная незнакомка?
Итак, прошу любить и жаловать – гигантская сколия (Megascolia maculata), самая крупная оса, да и, вообще, перепончатокрылое России и Европы! Самые крупные особи вырастают почти до пяти сантиметров в длину.
Кроме того, оса ярко окрашена, в потому её легко заметить, и немного запереживать за целостность своих кожных покровов 😉
Стоит ли их бояться?
Прежде чем ответить на этот вопрос, нужно узнать как живёт этот гигант макромира. А житие её очень интересное.
Проще всего сколию-гиганта можно встретить весной у трухлявых старых пней. И для несведущего человека непонятно, чем ей так интересен тот или иной пень. Но насекомое чувствует то, чего не чувствуем мы.
Где-то там, под пнём, ещё не ведая о смертельной опасности, затаилась личинка жука (обычно носорога или майского). Найдя её, сколия нанесёт ей "удар замедленной смерти", ужалив (а вы знаете, что жало у ос – видоизменённый яйцеклад), парализовав, а заодно отложив яйца.
Так личинка жука превращается в живые консервы для будущего потомства сколии. В остальном сколия милаха – питается цветочным нектаром и к людя не пристаёт. 😉
Вы спросите, а почему она не опасна, и почему мы все знаем шершня, но не знаем сколию? Всё дело в том, что сколия имеет ряд черт, которые способствуют её миролюбию.
Во-первых, это оса-одиночка. Соответственно она не призовёт на подмогу сестёр, если вы потревожите её.
Во-вторых яд её слабый, иначе она просто убивала бы свои "живые консервы".
В-третьих, в отличие от ос, производящих гнёзда, этой осе нечего защищать. Какой смысл вступать с вами в единоборство и рисковать, если драться ей не за что. Она просто перелетит на соседний цветок, или выберет себе другой "начинённый" пень неподалёку 😊
Ну, а у меня всё. Надеюсь вас развлёк мой небольшой очерк. Он составлен по материалам моего телеграм-канала "Планетяне". Если вам интересно каждый день узнавать о необычной природе нашей планеты, приглашаю на борт:
Trichia decipiens
Trichia decipiens - широко распространенный во всем мире вид слизевиков.
Плодовые тела (то, что на фото оранжевое) достигают 3 мм в высоту и 0,6-0,8 (редко до 1,3) мм в ширину.
Фотограф Yakup Karaduman.
Каменные миры Ч.2
Продолжение поста про макрофото камушков )
Каменные миры приятного просмотра )
1)
2)
3)
4)
5)
6)
7)
8)
9)
10)
11)
Пока что всё. позже выложу еще фоток. Я знаю, что вы не просили. Но я не могу остановиться )))
Спасибо за то, что порассматривали это красоту со мной. И да пребудет с вами Сила )

Крупный план головы жука-усача
Каменные миры
Доставала камушки из галтовки и не могла не сфотать эту пёструю красоту. Все камни мокрые, после 60 гриб карбида кремния в виброгалтовке. Форма не изменилась, но рисунок стал чуть более ярким. Все образцы не более 3х см размером.
Кстати про приключения с галтовкой пишут отдельный пост )
Будет длиннопост с кучей фоток ) Приятного просмотра.
Пс, посоветуйте пожалуйста бюджетный фотик с объективами для макрофото. Я вообще не шарю в фотоаппаратах, но понимаю что камеры телефона уже недостаточно.
1)
2)
3)
4)
5)
6)
С этим образцом вопросики. Вроде бы стоматолит (Риолит?). Но очень мелкие полоски. Размер этого образца около 1.5см
7)
8)
9)
10)
11)
12)
13)
14)
15)
16)
17)
18)
19)
20)
Это, конечно, еще не всё. Я выбрала самые фактурные экземпляры. Но пусть будет всего 20 фоток (ВСЕГО). Думаю, сделаю ещё 1 пост )
Оставила их ждать, пока доготавливаются другие камни. Дальше ждёт уже более мелкая обработка.
Пасибо что посмотрели. И да пребудет с вами Сила )